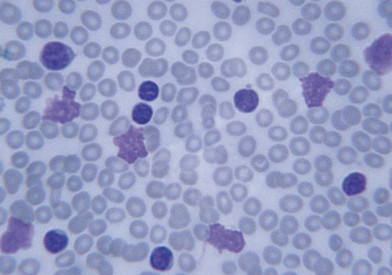
leukemia-cells657x443.jpg

Information for Health Care Professionals
Patient Referrals
To refer an adult patient, call 877-441-3324.
To refer a pediatric patient, call 888-733-4662.
To refer a patient online, complete the referral form.
Patient Transfers
Need to transfer a patient to Boston? Our team coordinates with receiving physicians and helps secure inpatient beds for patients coming from emergency departments or community hospitals.
Call to Request a Patient Transfer to Dana-Farber in Boston
For You, the Clinician
Dana-Farber is recognized worldwide as a leader in cancer diagnostics, treatments and research. We welcome the opportunity to work with you through the patient referral process; with continuing medical education offerings; and by sharing information about research advances, resources, and clinical trials.
For Your Patients
Planning Your In-Person Visit
Preparing for Your First Appointment
Insurance and Financial Information
Resources and Support Services
International Assistance
Interpreter Services
Clinical Affiliations and Resources
Clinical Advances
Clinical Affiliations
Clinical Resources
Cancer Diagnostic Service
Physician Gateway
Hematologic Malignancies Resources
Adult Stem Cell Transplant and Cellular Therapies
Pediatric Stem Cell Transplant Program
Education and Training
Continuing Medical Education
Fellowships and Training Programs
Office for Faculty Development (OFD)

Clinical Advances
Learn about Dana-Farber's newest advances in cancer research and care, current clinical trials, CME courses, and more.

Publications
Read the latest issues of Dana-Farber publications, including Paths of Progress and Turning Point. Learn of Dana-Farber's many advances in cancer care and research.

Treatment Centers and Clinical Services
We care for adults and children with cancer in our specialized treatment centers, focused on specific cancer types. Our teams of specialists work closely together to offer patients the latest therapies and clinical services, including access to innovative clinical trials.